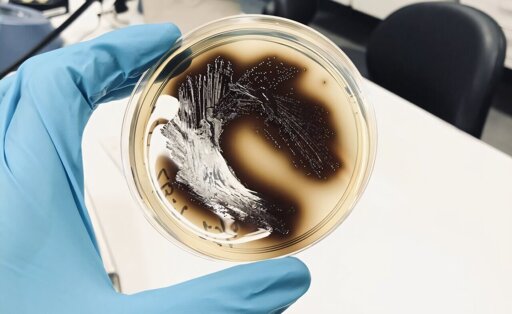

Bacteria in food can make you seriously ill, which is why it is so important for the facilities that produce your food to ensure proper hygiene in their production lines. A new doctoral thesis from NTNU has investigated how bacterial communities in the chicken and salmon industries change when disinfectants are used.
From Biology News - Evolution, Cell theory, Gene theory, Microbiology, Biotechnology via This RSS Feed.
You must log in or # to comment.